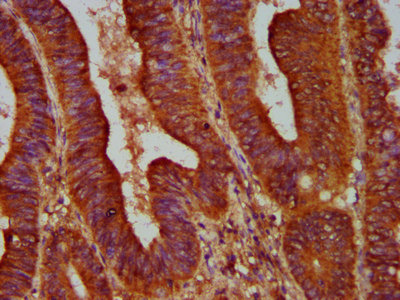

ALOX12 Antibody
-
中文名稱:ALOX12兔多克隆抗體
-
貨號:CSB-PA001617LA01HU
-
規(guī)格:¥440
-
圖片:
-
Western Blot
Positive WB detected in: K562 whole cell lysate, SH-SY5Y whole cell lysate
All lanes: ALOX12 antibody at 3.53µg/ml
Secondary
Goat polyclonal to rabbit IgG at 1/50000 dilution
Predicted band size: 76 kDa
Observed band size: 76 kDa -
IHC image of CSB-PA001617LA01HU diluted at 1:500 and staining in paraffin-embedded human colon cancer performed on a Leica BondTM system. After dewaxing and hydration, antigen retrieval was mediated by high pressure in a citrate buffer (pH 6.0). Section was blocked with 10% normal goat serum 30min at RT. Then primary antibody (1% BSA) was incubated at 4°C overnight. The primary is detected by a biotinylated secondary antibody and visualized using an HRP conjugated SP system.
-
IHC image of CSB-PA001617LA01HU diluted at 1:500 and staining in paraffin-embedded human skeletal muscle tissue performed on a Leica BondTM system. After dewaxing and hydration, antigen retrieval was mediated by high pressure in a citrate buffer (pH 6.0). Section was blocked with 10% normal goat serum 30min at RT. Then primary antibody (1% BSA) was incubated at 4°C overnight. The primary is detected by a biotinylated secondary antibody and visualized using an HRP conjugated SP system.
-
Immunofluorescence staining of A549 cells with CSB-PA001617LA01HU at 1:166, counter-stained with DAPI. The cells were fixed in 4% formaldehyde, permeabilized using 0.2% Triton X-100 and blocked in 10% normal Goat Serum. The cells were then incubated with the antibody overnight at 4°C. The secondary antibody was Alexa Fluor 488-congugated AffiniPure Goat Anti-Rabbit IgG(H+L).
-
-
其他:
產(chǎn)品詳情
-
產(chǎn)品名稱:Rabbit anti-Homo sapiens (Human) ALOX12 Polyclonal antibody
-
Uniprot No.:
-
基因名:
-
別名:12 LOX antibody; 12(S) lipoxygenase antibody; 12-lipoxygenase antibody; 12LO antibody; 12S LOX antibody; 12S-lipoxygenase antibody; 12S-LOX antibody; 12S-type antibody; Alox12 antibody; Arachidonate 12 lipoxygenase antibody; Arachidonate 12 lipoxygenase, 12S type antibody; Arachidonate 12-lipoxygenase antibody; Arachidonate 12-oxidoreductase antibody; Lipoxin synthase 12-LO antibody; LOG12 antibody; LOX12_HUMAN antibody; P-12LO antibody; Platelet 12-LOX antibody; Platelet type lipoxygenase 12 antibody; platelet-type 12-lipoxygenase antibody; Platelet-type lipoxygenase 12 antibody
-
宿主:Rabbit
-
反應(yīng)種屬:Human
-
免疫原:Recombinant Human Arachidonate 12-lipoxygenase, 12S-type protein (508-658AA)
-
免疫原種屬:Homo sapiens (Human)
-
標(biāo)記方式:Non-conjugated
本頁面中的產(chǎn)品,ALOX12 Antibody (CSB-PA001617LA01HU),的標(biāo)記方式是Non-conjugated。對于ALOX12 Antibody,我們還提供其他標(biāo)記。見下表:
-
克隆類型:Polyclonal
-
抗體亞型:IgG
-
純化方式:>95%, Protein G purified
-
濃度:It differs from different batches. Please contact us to confirm it.
-
保存緩沖液:Preservative: 0.03% Proclin 300
Constituents: 50% Glycerol, 0.01M PBS, pH 7.4 -
產(chǎn)品提供形式:Liquid
-
應(yīng)用范圍:ELISA, WB, IHC, IF
-
推薦稀釋比:
Application Recommended Dilution WB 1:500-1:5000 IHC 1:500-1:1000 IF 1:50-1:200 -
Protocols:
-
儲存條件:Upon receipt, store at -20°C or -80°C. Avoid repeated freeze.
-
貨期:Basically, we can dispatch the products out in 1-3 working days after receiving your orders. Delivery time maybe differs from different purchasing way or location, please kindly consult your local distributors for specific delivery time.
-
用途:For Research Use Only. Not for use in diagnostic or therapeutic procedures.
相關(guān)產(chǎn)品
靶點(diǎn)詳情
-
功能:Catalyzes the regio and stereo-specific incorporation of molecular oxygen into free and esterified polyunsaturated fatty acids generating lipid hydroperoxides that can be further reduced to the corresponding hydroxy species. Mainly converts arachidonate ((5Z,8Z,11Z,14Z)-eicosatetraenoate) to the specific bioactive lipid (12S)-hydroperoxyeicosatetraenoate/(12S)-HPETE. Through the production of bioactive lipids like (12S)-HPETE it regulates different biological processes including platelet activation. It can also catalyze the epoxidation of double bonds of polyunsaturated fatty acids such as (14S)-hydroperoxy-docosahexaenoate/(14S)-HPDHA resulting in the formation of (13S,14S)-epoxy-DHA. Furthermore, it may participate in the sequential oxidations of DHA ((4Z,7Z,10Z,13Z,16Z,19Z)-docosahexaenoate) to generate specialized pro-resolving mediators (SPMs) like resolvin D5 ((7S,17S)-diHPDHA) and (7S,14S)-diHPDHA, that actively downregulate the immune response and have anti-aggregation properties with platelets. An additional function involves a multistep process by which it transforms leukotriene A4/LTA4 into the bioactive lipids lipoxin A4/LXA4 and lipoxin B4/LXB4, both are vasoactive and LXA4 may regulate neutrophil function via occupancy of specific recognition sites. Can also peroxidize linoleate ((9Z,12Z)-octadecadienoate) to (13S)-hydroperoxyoctadecadienoate/ (13S-HPODE). Due to its role in regulating both the expression of the vascular endothelial growth factor (VEGF, an angiogenic factor involved in the survival and metastasis of solid tumors) and the expression of integrin beta-1 (known to affect tumor cell migration and proliferation), it can be regarded as protumorigenic. Important for cell survival, as it may play a role not only in proliferation but also in the prevention of apoptosis in vascular smooth muscle cells.
-
基因功能參考文獻(xiàn):
- ALOX15 orthologs, commonly known as 12/15-lipoxygenases, were suggested to exhibit mainly arachidonic acid 12-lipoxygenating specificity in mammals ranked in evolution lower than gibbons and 15-lipoxygenating specificity in the higher ranking primates [Review]. PMID: 30237084
- ALOX12 rs14309 GG genotype expression was found to be significantly associated with Cardiovascular events in patients with Diabetic Nephropathy. PMID: 29196930
- Data suggest that ALOX12 is involved in oxidative stress and endoplasmic reticulum stress in liver and other tissues leading to non-alcoholic fatty liver disease. [REVIEW] PMID: 28886991
- 12(S)-HETrE, a 12-lipoxygenase oxylipin of dihomo-gamma-linolenic acid, inhibits thrombosis via Galphas signaling in platelets. PMID: 27470510
- Results identified a novel ALOX12 locus (indicated by two SNPs in perfect linkage disequilibrium: rs1042357 and rs10852889) that moderated the association between PTSD and reduced thickness of the right prefrontal cortex. PMID: 26372769
- The regulation of important oxylipin metabolic genes in peripheral blood mononuclear cells varied with the extent of change in arachidonic acid concentrations in the case of PTGS1 and ALOX12 regulation. PMID: 26672987
- ITGB4 stimulation leads to recruitment of 12-LOX from the cytosol to the membrane. PMID: 26037302
- In the highest tertile with ALOX12. PMID: 25339205
- the amount of LPL expressed in muscle and heart governed both the binding of chylomicron particles and the assimilation of chylomicron lipids in the tissue. PMID: 25598081
- Results suggest that Alox12 protein polymorphisms did not discriminate for psoriasis severity. PMID: 24975552
- Results indicate that secreted phospholipase A2 IIA (sPLA2-IIA) as an enzyme working in concert with platelet microparticles (MPs) 12-lipoxygenase (12-LO) to promote internalization. PMID: 26106157
- IGF-1 reduces lipid oxidation and foam cell formation via downregulation of 12/15-LOX to prevent atherosclerosis. PMID: 25549319
- The 12/15-lipoxygenase as an emerging therapeutic target for Alzheimer's disease PMID: 25708815
- The costaining of pancreatic polypeptide and vimentin suggests that 12-LO participates in the process leading to beta-cell dedifferentiation in the islet. PMID: 25532042
- The ALOX12 levels were relatively decreased in nasal polyp tissue. PMID: 22991985
- Inhibition of 12-LOX activity significantly sensitizes prostate cancer cells to radiation. PMID: 25260086
- Our goal was to investigate if 12-LOX and/or PAI-1 in patient's plasma could be used to predict outcome of the disease. PMID: 24783193
- There was no statistically significant difference in expression of ALOX12 mRNA in cholesteatoma vs. control tissue. PMID: 23832258
- This study demonstrated the critical role ALOX12 plays in T. gondii infection in humans, using a monocytic cell line with an ALOX12 knockdown. PMID: 24686056
- 12-LOX 261Arg > Gln polymorphism is associated with rectal cancer. PMID: 23715757
- PAR4 and GPVI-mediated platelet reactivity involves 12-lipoxygenase PMID: 23784669
- The results of our study failed to confirm whether the selected variants in ALOX12 gene within the LT metabolism pathway contribute to platelet reactivity in a diabetic population treated with ASA. PMID: 23828562
- Our results suggest that LOX metabolites such as 12-HETE are critical in prostate cancer progression and that the LOX pathway may be a target for treating and preventing prostate cancer. PMID: 22895552
- the authors have identified a new pathway by which overexpression of 12-LOX in prostate cancer cells leads to augmented production of MMP9 via activation of PI3K/Akt/NF-kappaB signaling. PMID: 23526143
- The LOX isozymes 12 and 15 contribute differentially to striatal vulnerability in response to neurotoxicant challenge. PMID: 23079635
- Findings suggest 12/15-LOX expressed in non-epithelial cells such as macrophages and fibroblasts leads to bronchial epithelial injury. PMID: 23528921
- Pharmacological inhibition and antisense knockdown of 12LO results in apoptosis of human vascular smooth muscle cells. PMID: 23578768
- increased 15-LOX-1 and decreased 5- and 12-LOX levels at the onset of kidney cancer reversing with the progressing stage of the disease or the grade of tumor PMID: 22825379
- Non-synonymous polymorphism (Gln261Arg) of 12-lipoxygenase is associated with colorectal and thyroid cancers. PMID: 22864639
- results show an increase of ALOX15B during the differentiation of monocytes to macrophages, while the expression of ALOX12 and ALOX15 remains on the same low level. PMID: 22980500
- results suggest that genetic variations in arachidonate 12-lipoxygenase (ALOX12) are associated with both the onset and cessation of menstruation in Chinese women living in Shanghai PMID: 22668814
- DNA methylation analysis of ALOX12 and GSTM1 in acute myeloid leukaemia identifies prognostically significant groups. PMID: 22924777
- The results suggest that the genetic polymorphisms in both human ALOX12 and ALOX15 may contribute to variations in the peak BMD of Chinese women. PMID: 22089472
- ALOX12 may have a role in growth of breast cancer, and its inhibition may be a strategy for inhibiting tumor growth PMID: 22384268
- DNA hypomethylation associated with persistent wheezing in childhood PMID: 22323304
- 12(S)-LOX expression in inflammatory areas of colorectal tumours has the capacity to induce an invasive phenotype in colorectal cancer cells and could be targeted for therapy. PMID: 22237009
- Overexpression of 12/15-lipoxygenase leads to increased levels of beta-secretase-1 mRNA and protein, a significant elevation in amyloid beta levels and deposition, and a worsening of memory deficits in Alzheimer's disease transgenic mice. PMID: 22275252
- genetic variants in ALOX12 may influence BMD and fracture risk. PMID: 21104233
- This study for the first time had co-related the quantity of serum LOX-12 with breast cancer and also with the effect of chemotherapy. PMID: 21945939
- 12-LOX may serve as a unique marker and therapeutic target for prostate cancer stem cells PMID: 21225230
- the rs2073438 polymorphism of ALOX12 contributes to the variation of obesity phenotypes in young Chinese men PMID: 20697415
- Data suggest that the development of combinatory therapies that profit from the ACSL4, lipooxygenase and COX-2 synergistic action may allow for lower medication doses and avoidance of side effects. PMID: 21085606
- Protease-activated receptor signaling in platelets activates cytosolic phospholipase A2alpha differently for cyclooxygenase-1 and 12-lipoxygenase catalysis. PMID: 21127289
- Genetic absence of this enzyme results in a significant reduction in amyloid-beta (Abeta) production and deposition and an improvement of cognitive deficits. PMID: 20570249
- the 12 and 15 ALOX expression, localization and downstream cytokine expression in subcutaneous and omental adipose tissue in human obesity were shown. PMID: 21094135
- Thrombin-activated human platelets acutely generate oxidized docosahexaenoic-acid-containing phospholipids via 12-lipoxygenase PMID: 20653566
- The mRNA levels of ALOX12 implicated pathways differed significantly in gliomas according to the histological type. PMID: 20382140
- we suggest that single nucleotide polymorphisms of the ALOX12 gene might be associated with schizophrenia and negative symptoms in this Korean population PMID: 20626912
- Two single-nucleotide polymorphisms, rs9904779 and rs434473 (encodes a replacement of asparagine by serine), of arachidonate 12-lipoxygenase were significantly associated with age at natural menopause PMID: 20061896
- ALOX12 is a direct transcriptional target of RUNX1. PMID: 20181616
顯示更多
收起更多
-
相關(guān)疾病:Esophageal cancer (ESCR); Colorectal cancer (CRC)
-
亞細(xì)胞定位:Cytoplasm, cytosol. Membrane. Note=Membrane association is stimulated by EGF.
-
蛋白家族:Lipoxygenase family
-
組織特異性:Expressed in vascular smooth muscle cells.
-
數(shù)據(jù)庫鏈接:
Most popular with customers
-
-
YWHAB Recombinant Monoclonal Antibody
Applications: ELISA, WB, IHC, IF, FC
Species Reactivity: Human, Mouse, Rat
-
Phospho-YAP1 (S127) Recombinant Monoclonal Antibody
Applications: ELISA, WB, IHC
Species Reactivity: Human
-
-
-
-
-